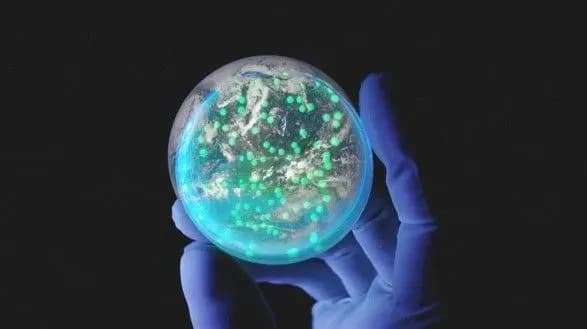
Ізраїль проведе серію наукових експериментів у космосі в співпраці з європейцями

Ізраїль проведе серію наукових експериментів у космосі в співпраці з європейцями
Київ • УНН
КИЇВ. 31 липня. УНН. Ізраїль проведе в космічному просторі чотири наукових експерименту у співпраці з Європейським космічним агентством (ЄКА). Про це повідомляє газета The Jerusalem Post, передає УНН.
“Ця програма стане частиною космічної місії ЄКА і буде здійснюватися у співпраці з ізраїльськими Міністерством науки і технологій та компанією Space Pharma. Мета проекту — надати вченим можливість проведення експериментів над бактеріями в умовах відкритого космосу”, — пише газета. Як пояснив один з учасників дослідження з ізраїльського медичного центру “Шиба”, можливість направити в космос матеріали для проведення подібних експериментів надається дослідницьким групам дуже рідко, можна сказати, що вона є унікальною.
ЧИТАЙТЕ ТАКОЖ: Українські школярі зможуть відправляти свої розробки в космос
У космосі після запуску в жовтні будуть проведені чотири ізраїльських наукових експерименти з вивчення бактерій, які були відібрані з великої кількості заявок, зазначає The Jerusalem Post. За інформацією видання, основне дослідження підготовлено групою ізраїльських та італійських вчених, а його метою є вивчення реакції бактерій на антибіотики в умовах відсутності земної гравітації.
В ході ще двох експериментів вчені мають намір досліджувати здатність деяких ферментів руйнувати викликають захворювання бактеріальні культури і здатність білка альбуміну прикріплятися до молекул крові, що важливо для правильного функціонування імунної системи. Четвертий експеримент буде присвячений виявленню кореляції між поведінкою молекул ДНК і старінням клітин людського організму, вказує газета.
Нагадаємо, китайський зонд здійснив біологічний експеримент на Місяці.